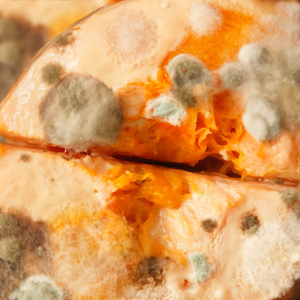
发霉食物图片

食用菌杂菌感染图片

把污染的菌袋从培养室淘汰出去,进行深埋或者烧毁,避免杂菌继续蔓延.
图片尺寸600x380
因为专家们也尚不清楚人类是如何感染到这种病毒的.
图片尺寸629x429
感染者的双腿
图片尺寸1080x701
竞争性杂菌病虫害
图片尺寸800x621
主要的感染人群在非洲.
图片尺寸640x316
根据近日公布的最新统计数据,由食肉菌感染引起的buruli溃疡病例
图片尺寸1080x621
152f20be01054daa8701702e65cce72e.jpg
图片尺寸1080x1440
食用菌细菌性病害的防治
图片尺寸768x1024
简介蘑菇绿霉病可为害多种食用菌子实体及菌种,是食用菌菌种生产和代
图片尺寸800x626
病例欣赏孢子丝菌病5
图片尺寸1024x683
吉林省的流行病—孢子丝菌病 - 好大夫在线
图片尺寸522x320
非常严重的袍子丝菌病
图片尺寸1024x768
在这个国家,每年大约有一千人感染坏死性筋膜炎.
图片尺寸615x410
香菇菌棒长满白毛,急需治疗!
图片尺寸1080x1440
食用菌防止杂菌污染的新型技术方法
图片尺寸650x420
蔬菜-食用菌 >> 鸡腿菇 >> 鸡腿菇绿霉病
图片尺寸800x532
双孢菇褐腐病的症状及解决方法
图片尺寸550x350
发霉食物图片
图片尺寸300x300
是由申克孢子丝菌所引起的皮肤,皮下组织及其邻近淋巴系统的慢性感染
图片尺寸1280x1024
简介蘑菇绿霉病可为害多种食用菌子实体及菌种,是食用菌菌种生产和代
图片尺寸800x626